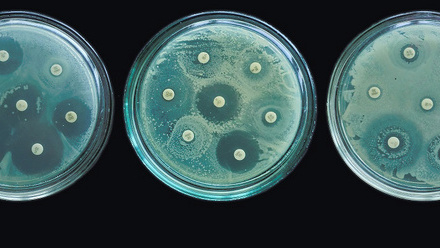
DS AMR image July 2023 resize.jpg

Displaying 5 of 5 results
Welcome to our document library – our powerful document search that allows you to filter resources by type, specialty and date of publication. Use the fields on the right-hand side to enter a keyword and then tick the filters below to refine your search.
Active filters: